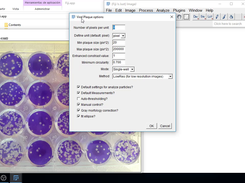
ViralPlaque Screenshot 2

Plaque assay has been used for a long time to determine infectious titers. We present ViralPlaque, a fast, open-source and versatile ImageJ macro for the automated determination of viral plaque dimensions from digital images. Also, a machine learning plugin is integrated in the analysis algorithm for adaptation of ViralPlaque to the user’s needs and experimental conditions. A high correlation between manual and automated measurements of plaque dimensions was demonstrated. This macro will facilitate reliable and reproducible characterization of cytolytic viruses with an increased processing speed. For more information please go to :
https://peerj.com/articles/7729/
If you want to ONLY count plaques please try:
https://sourceforge.net/projects/viralcounter/
If you think my work is useful you can buy me a coffee! https://www.buymeacoffee.com/mcacciabue
ViralPlaque
A fast, open-source and versatile ImageJ macro for the automated dete
Brought to you by:
marcocacciabue
Downloads:
6 This Week